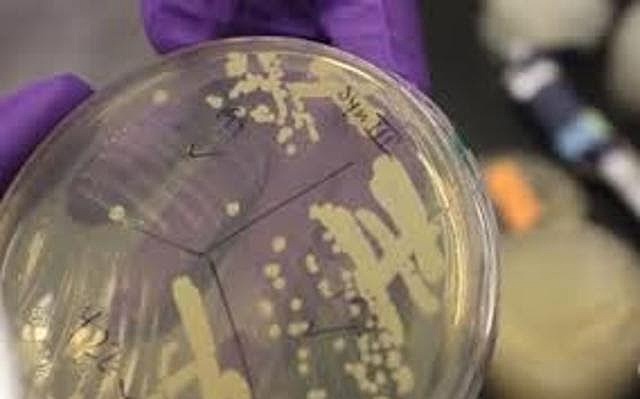
Cromosoma sintetico

-
A partir del pus de vendajes quirúrgicos y de las células que estaban presentes ahí separo los núcleos y comprobó que en estos había una sustancia química a la que denomino "NUCLEINA"(ÁCIDOS NUCLEICOS).
-
Descifro la química de la nucleina y proteínas presentes en ella, había demostrado que la nucleína de Miescher contenía proteínas, sustancias básicas ricas en nitrógeno y un glúcido de cinco átomos de carbono.Lo que hoy se conoce como bases nitrogenadas.
-
Utiliza técnicas fisicoquimicas para describir la nucleina, debido a sus características las llama Ácidos nucleicos.
-
Postulan que las unidades de herencia se encuentran localizadas en unas estructuras filamentosas denominadas cromosomas.
-
Indica que los genes se encuentran en lugares específicos dentro de los cromosomas y que el comportamiento de los cromosomas durante la meiosis puede explicar las leyes de la herencia de Mendel.
-
Demostró que los cromosomas son portadores de los genes.
-
Descubre que los cromosomas son las unidades discretas heredables.
-
Mapas cromosómicos y genes ligados al sexo.
-
Identifica los componentes del ácido nucleico, da las primeras luces del esqueleto Azúcar-Base nitrogenada. En 1909 identifica la ribosa, en 1929 a la desoxiribosa. En 1926 propone una conformación de los ácidos nucleicos: el tetranucleótido plano.
-
Decian que el ADN solo se encontraba presente en los animales y que el ARN solo estaba en las plantas.
-
Demostró que las bacterias eran capaces de transferir información genética mediante un proceso llamado transformación. Investigando una enfermedad infecciosa mortal, la neumonía, estudió las diferencias entre una cepa de la bacteria Streptococcus pneumoniae que producía la enfermedad y otra que no la causaba.
-
Determino que el núcleo es el encargado de controlar el desarrollo del organismo.
-
Concluyeron que el ADN es un polímero.
-
Extrae el ADN puro de plantas y demuestra que las plantas tienen los dos tipos de nucleotidos.
-
Gracias a sus estudios de difracción por rayos X, descubrieron y propusieron que el ADN era una fibra compuesta de bases nitrogenadas apiladas a 0.33 nm unas de otras, sus experimentos ayudo a que se acuñara la biologia molecular como un area independiente.
-
Descubrieron que había una correlación entre las enzimas y los genes, conocido como la hipótesis “Un gen, una enzima”.
-
Postularon que las mutaciones son las causantes de la resistencia de las bacterias a fármacos.
-
Describen el ADN como la molecula responsable de la transferencia de los caracteres hereditarios.
-
Analizó las bases nitrogenadas del ADN en diferentes formas de vida, concluyendo que, la cantidad de purinas no siempre se encontraban en proporciones iguales a las de las pirimidinas (contrariamente a lo propuesto por Levene).
-
Primer tARN aislado.
-
Realizaron experimentos para demostrar que el ADN es la base del material genetico, de la herencia y no las proteínas.
-
Descubrieron que el ADN se encuentran en forma de doble hélice, configuraban una escalera que se iba doblando, cuyos "peldaños" eran las bases nitrogenadas unidas por enlaces de hidrógeno y las "barandas" o armazón, los azúcares y fosfatos.
-
Establecieron el numero correcto de los cromosomas humanos.
-
Descubre la replicacion del ADN ademas de detallarlo
-
Demostraron el mecanismo semiconservativo del ADN.
-
Aíslan primera enzima de restricción.
-
Es el primero en crear una molécula de ADN recombinante.
-
CLONACION DEL cDNA DEL GEN DE LA INSULINA HUMANA.
-
Ambos investigadores lograron descubrir, por separado, que los genes pueden aparecer dentro del material genético en varios segmentos bien diferenciados.
-
Desarrolla el mecanismo de secuenciación automatizada del ADN.
-
Se clona el primer mamifero a partir de una celula adulta.
-
Se logra hacer el primer trasplante de un genoma completo de una bacteria hacia otra bacteria.
-
Crean el primer cromosoma artificial de la historia a partir de levadura.
-
Se logra cambiar células a su estado similar al embrionario, Shinya Yamanaka, basado en una combinación de 4 genes.
-
Este busca caracterizar la funcionalidad del genoma humano.
Want to make a timeline like this?
Use Timetoast to turn dates, events, milestones, and phases into a clear visual timeline you can build and share. Timetoast is a timeline maker for work, school, research, and stories.